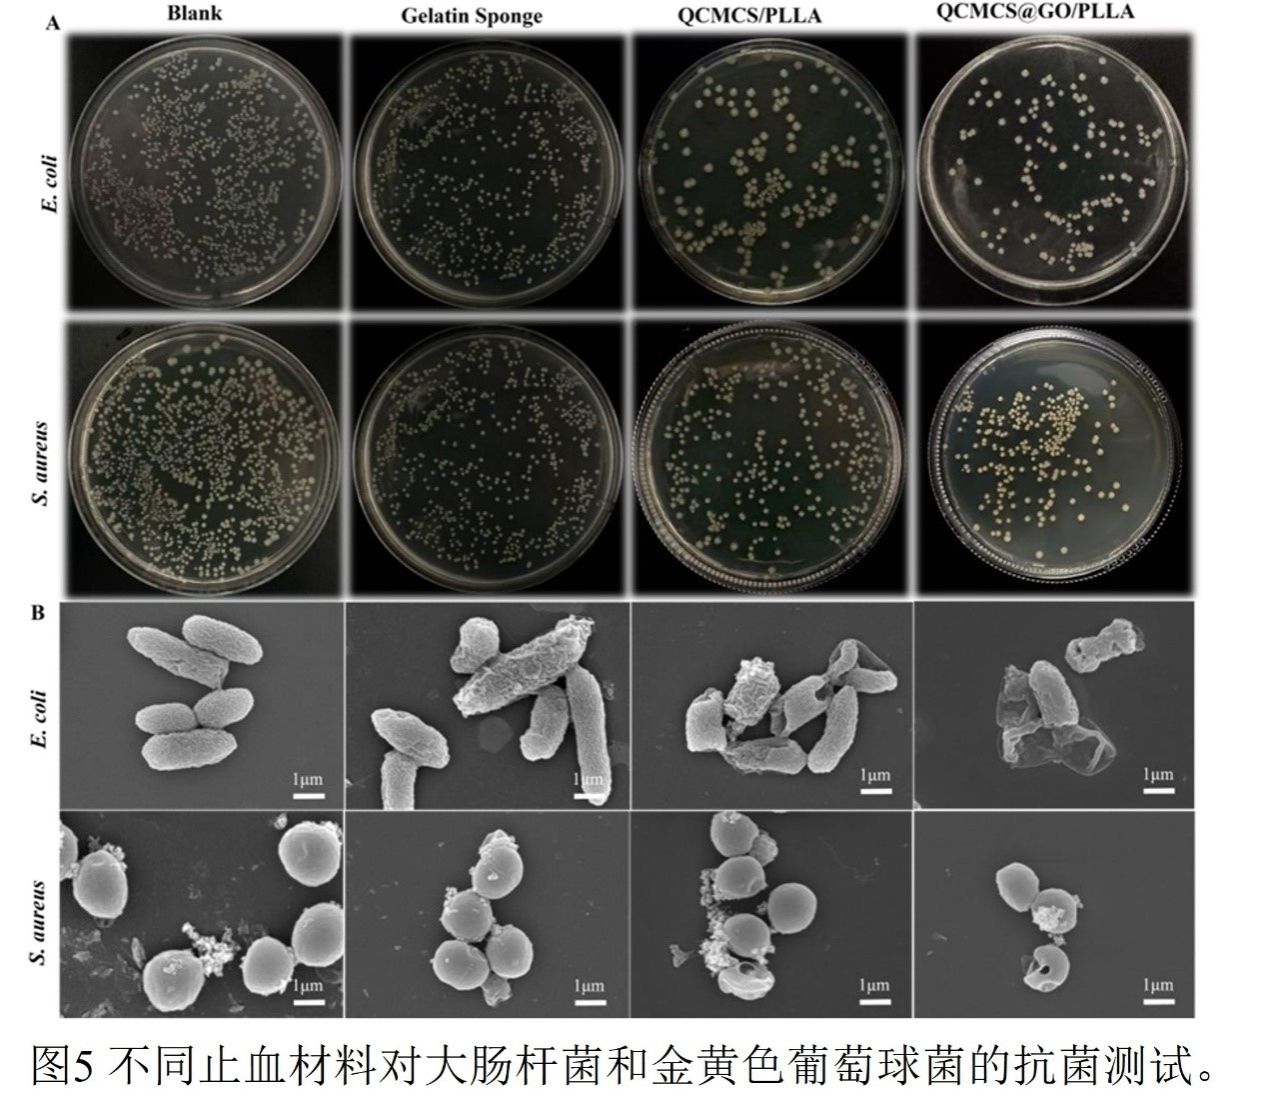

发布时间:2026-02-03
发布时间:2026-02-03 浏览次数:
浏览次数:
近日,一项由新疆师范大学化学化工学院王英波教授团队主导的研究,成功开发出一种多功能双层海绵伤口敷料。该研究成果以“A Hierarchical Bilayer Sponge Dressing Based on QCMCS@GO/PLA for Synergistic Wound Healing via Hemostasis and Anti-Adhesion”为题,发表于中科院2区TOP期刊《International Journal of Biological Macromolecules》(IF=8.5)。硕士研究生蒋海水为第一作者。
本工作致力于解决临床伤口管理中的关键难题:止血效率低、易感染和易形成生物膜。据统计,约35%的创伤相关死亡与过量失血及继发感染相关。目前常用的商业敷料(如明胶海绵)功能单一,难以在复杂伤口环境中同时实现快速凝血、高效抗菌和持续抗粘连的多重目标。因此,开发一种集成化的多功能伤口敷料已成为紧迫需求。
在材料层面,单一组分难以满足所有要求。氧化石墨烯(GO)能促进凝血并具有物理抗菌性,但其湿态机械稳定性差;季铵化羧甲基壳聚糖(QCMCS)具有优异的止血和接触抗菌能力,但在水中易溶胀,机械性能下降;聚乳酸(PLLA)纳米纤维膜能作为疏水屏障有效防止细菌粘附,但本身缺乏主动止血功能。如何将这些材料的优势协同整合,并阐明其协同作用机制,是当前复合材料设计面临的主要挑战。
基于上述问题与挑战,本工作提出了一种创新的仿生双层设计策略。该策略并非创造新物质,而是对成熟材料(QCMCS、GO、PLLA)进行理性整合,构建一个功能分级的双层系统:顶层为超疏水PLLA纳米纤维屏障,用于抵抗细菌粘附;底层为QCMCS@GO复合海绵,负责快速止血和主动抗菌。该设计旨在通过物理结构与化学功能的时空协同,系统解决“止血-抗感染-促愈合”的连续性临床需求,为开发下一代智能伤口敷料提供新的思路和实验依据。
根据扫描电子显微镜(SEM)图像观察,原始QCMCS@GO海绵层呈现出三维互联的多孔网络结构,而PLLA层则由致密堆叠的纤维组成。双层结构通过静电自组装稳定结合,避免了界面分层可能造成的二次损伤。材料表面的接触角测试清晰地揭示了外层PLLA(124°)与内层QCMCS/GO海绵(46°)之间显著的亲疏水差异。傅里叶变换红外光谱(FTIR)分析进一步证实,复合物中各组分特征峰得以保留,未出现新的化学键,表明QCMCS与GO之间以及PLLA层与QCMCS@GO基底之间主要通过静电吸附、范德华力等物理相互作用结合,形成了物理关联的双层结构。这种结合方式在有效维持各层结构和功能独立性的同时,避免了化学交联剂可能引入的生物毒性。

图1
通过系统研究GO掺杂量(0-0.5 wt%)对海绵性能的影响发现,当GO含量为0.1 wt%时,复合海绵达到最优综合性能:其吸液率高达3660.71%±128.27%(较无GO对照组提升约27%),孔隙率达91.72%±0.92%。机理上,GO纳米片与QCMCS分子链之间通过氢键形成三维互联网络,增强了孔隙连通性与毛细作用力。然而,当GO含量增至0.5 wt%时,吸液率显著下降至2851.14%±62.61%,孔隙率亦明显降低。SEM图像表明,过高的GO含量会导致纳米片堆叠,引起孔隙堵塞与孔壁断裂,形成结构缺陷与应力集中。凝血性能测试同样呈现明显的剂量-效应关系:0.1 wt% GO组具有最低的凝血指数(BCI=18.62%±0.73%),展现出最优的凝血活性与良好的血液相容性;当GO添加量增至0.5 wt%时,BCI值反弹,溶血现象显著加剧,这主要归因于GO团聚形成的物理屏障阻碍了其与血液成分的有效接触。

图2
PLLA溶液浓度(0.1-0.2 g/mL)通过静电纺丝工艺显著影响纤维形貌及其性能。当浓度提升至0.15 g/mL时,纤维直径增至229.79 ± 5.77 nm,水接触角达到124°,表明其微纳级粗糙度有效增强了材料疏水性。在此条件下制备的纤维膜表现出最低的细菌渗透率(3.49%),这归因于其优化的孔径分布能有效物理阻隔病原体。然而,当浓度进一步升高至0.2 g/mL时,过度的纤维堆叠导致结构致密化,致使接触角回降至109°,细菌渗透率反弹至6.51%。非对称润湿性设计优化了材料对伤口微环境的适应性:亲水的内层(接触角46°)加速了血液吸收与扩散,而疏水的外层(124°)则有效阻挡了外部污染物。该双层体系通过功能分层,实现了对微环境调控与凝血性能的协同增强。

图3
体外凝血性能的系统评估揭示了QCMCS@GO/PLLA海绵优异的促凝活性及其分子机制。动态凝血指数(BCI)分析显示,QCMCS@GO/PLLA组在1分钟时的BCI值(26.79%)显著低于未修饰GO的QCMCS/PLLA组(32.60%),表明GO修饰显著加快了凝血启动。5分钟时其BCI值进一步降至18.24%,凝血效率较未修饰组提升28.6%。全血凝固时间(WBCT)测试进一步证实了GO的促凝作用:QCMCS@GO/PLLA组的凝固时间仅为312秒,较空白组缩短47.6%。扫描电镜(SEM)观察显示,复合材料表面的红细胞吸附率达46.5%,且细胞从典型的双凹圆盘状转变为多边形(表明细胞被激活);血小板吸附率提升至48.53%,并观察到明显的伪足延伸和纤维蛋白网络形成。凝血途径选择性实验表明GO主要作用于内源性途径:活化部分凝血活酶时间(APTT)缩短至21.33秒(减少26.7%),而凝血酶原时间(PT)仅轻微缩短(减少7.5%)。凝血酶(FIIa)生成测定证实QCMCS@GO/PLLA组具有最强的促凝活性。这些结果共同揭示了GO通过其高比表面积(500 m⟡/g)浓缩凝血因子,并以其表面负电荷特异性激活内源性凝血途径中的因子XII,从而基于物理吸附和化学激活的双重机制协同加速凝血过程

图4
系统化的生物相容性评估证实了QCMCS@GO/PLLA海绵具有良好的血液相容性、低细胞毒性及显著的促细胞迁移能力。溶血实验显示,在0.5–2 mg/mL浓度范围内,材料溶血率保持在2.78%–4.16%之间,显著低于ISO 10993-4标准规定的5%安全阈值,这归因于材料表面的电荷平衡设计:QCMCS链段中的季铵基团提供正电界面促进血小板粘附,而GO纳米片上的羧基通过静电相互作用稳定红细胞膜结构。CCK-8细胞毒性测试进一步证实了材料的良好生物相容性:在最佳浓度0.5 mg/mL下,L-929成纤维细胞在第1天和第3天的存活率分别为90.23%和94.82%,均显著高于ISO 10993-5标准要求的>70%。存活/死亡染色结果显示活细胞(绿色,Calcein-AM标记)占总细胞数的95%以上,死细胞(红色,PI标记)稀疏分布,表明材料未显著损害细胞膜完整性或线粒体功能。划痕迁移实验定量分析表明,与空白对照组相比,QCMCS@GO/PLLA处理组的细胞迁移率显著提升:24小时划痕愈合率达到52.33%±3.21%(对照组为23.0%±2.5%),48小时进一步提升至85.66%±2.47%(对照组为48.66%±3.05%)。实验组在24至48小时内的愈合面积绝对增幅(+33.33%)也显著高于对照组(+25.66%),表明该材料不仅能启动细胞迁移,还能持续增强细胞运动能力。该材料通过物理结构、表面化学与代谢调控的协同整合,实现了从传统被动止血到主动修复的功能跃迁。
图5
抗菌性能研究表明,QCMCS@GO/PLLA海绵对革兰氏阳性金黄色葡萄球菌和革兰氏阴性大肠杆菌均展现出广谱高效抗菌活性,其抗菌率分别达86.36%和89.34%。该性能显著优于未添加GO的对照组及明胶海绵对照组。抗菌机制研究揭示了一个三重协同作用体系:1) 物理破坏:高比表面积的GO纳米片凭借其锋利边缘可直接切割并穿透细菌细胞膜,SEM图像清晰观察到细菌外膜塌陷、穿孔及细胞质泄漏等形态损伤;2) 化学氧化:GO作为电子受体可催化产生活性氧,通过氧化应激途径增强杀菌效果;3) 物理屏障:表面超疏水(接触角124°)的PLLA纳米纤维层能有效抑制细菌初始粘附,其细菌阻隔率高达99%,从而从源头上防止生物膜形成。荧光染色结果进一步验证了该材料对细菌的致死效果,尤其是对大肠杆菌的破坏作用更为显著。该研究为构建集快速止血与高效抗感染于一体的多功能敷料提供了坚实的实验基础。

图6
动物体内实验证实QCMCS@GO/PLLA海绵在复杂出血场景中具有快速、强效的止血能力与良好的生物相容性。在大鼠肝脏穿透伤模型中,该海绵的止血时间仅为107±8秒,失血量仅为0.22±0.03克,与明胶海绵对照组相比,止血时间缩短53%,失血量减少49%。在大鼠尾部离断动脉出血模型中,该材料同样表现优异,止血时间(118±14秒)较对照组缩短60.7%。组织学分析显示,材料的主要器官(心、肝、脾、肾)未见明显的组织损伤、炎症病变或其他病理异常,表明其具有良好的体内生物安全性。这些结果综合验证了该材料在实际生理环境中的高效止血性能与临床转化潜力。
本工作成功制备了一种基于静电纺丝与冷冻干燥技术的QCMCS@GO/PLLA双层海绵敷料。该材料采用仿生层级设计,上层为疏水PLLA纳米纤维屏障,有效抵抗细菌粘附;下层为亲水QCMCS@GO复合海绵,具备快速止血与主动抗菌功能。两层通过物理作用稳定结合,在维持各自功能独立性的同时避免了化学交联的潜在毒性。
该材料展现出优异的综合性能:在体外及动物模型中均能实现快速凝血,止血时间较商业明胶海绵缩短53%以上;对金黄色葡萄球菌和大肠杆菌的抗菌率均高于86%,并显著减少细菌表面粘附;同时具有良好的生物相容性,能显著促进细胞迁移与组织修复。该研究为开发集止血、抗感染与促愈合于一体的多功能伤口敷料提供了有效的材料解决方案,在难愈性创伤临床治疗中具有重要应用潜力。
第一作者:蒋海水,男,新疆师范大学无机化学专业2026届硕士毕业生。主要从事基于伤口微环境响应的药物递送系统设计、可控制备与其医用研究,目前以第一作者身份在Advanced Materials Technologies和International Journal of Biological Macromolecules上发表研究型论文2篇。曾获第三届中国生物纳米酶大会优秀学术墙报奖、研究生自治区奖学金、中国国际大学生创新大赛(2025)自治区银奖等荣誉。

王英波教授领衔的生物医用团队
王英波,女,博士,中共党员,博士生导师/博士后导师,新疆师范大学化学化工学院副院长。自治区人才项目入选者,新疆化学学会优秀青年科技奖获得者(2017),新疆储能与光电催化材料自治区重点实验室主任,新疆师范大学化学重点学科负责人(2019),化学工程与工艺自治区一流专业负责人,材料与化工学术带头人,中国生物材料学会委员、中国复合材料学会生物复合材料分会委员及新疆新材料产业联合体专家委员。承担结构化学、材料制备与表征等本硕课程。从事生物材料开发及应用,以及药物缓释及应用研究。主持国家自然科学基金3项、省部级以上课题5项。以第一作者/通讯作者在ACS applied materials & interfaces、Materials Today Chemistry、Journal of advanced research、J. International journal of biological macromolecules、Materials & Design、《高等学校化学学报》等发表论文40余篇,其中SCI论文30余篇。申请发明专利13项,其中授权7项。指导本硕博学生获得自治区级科技创新项目13项;指导本硕博学生中国国际互联网+大赛,斩获国家银奖2项、国铜1项,省赛金1项、银奖2项、铜奖7项。培养硕士研究生26名,博士研究生5名、博士后2人。
信息、图片来源:化学化工学院 编审:宣传部
